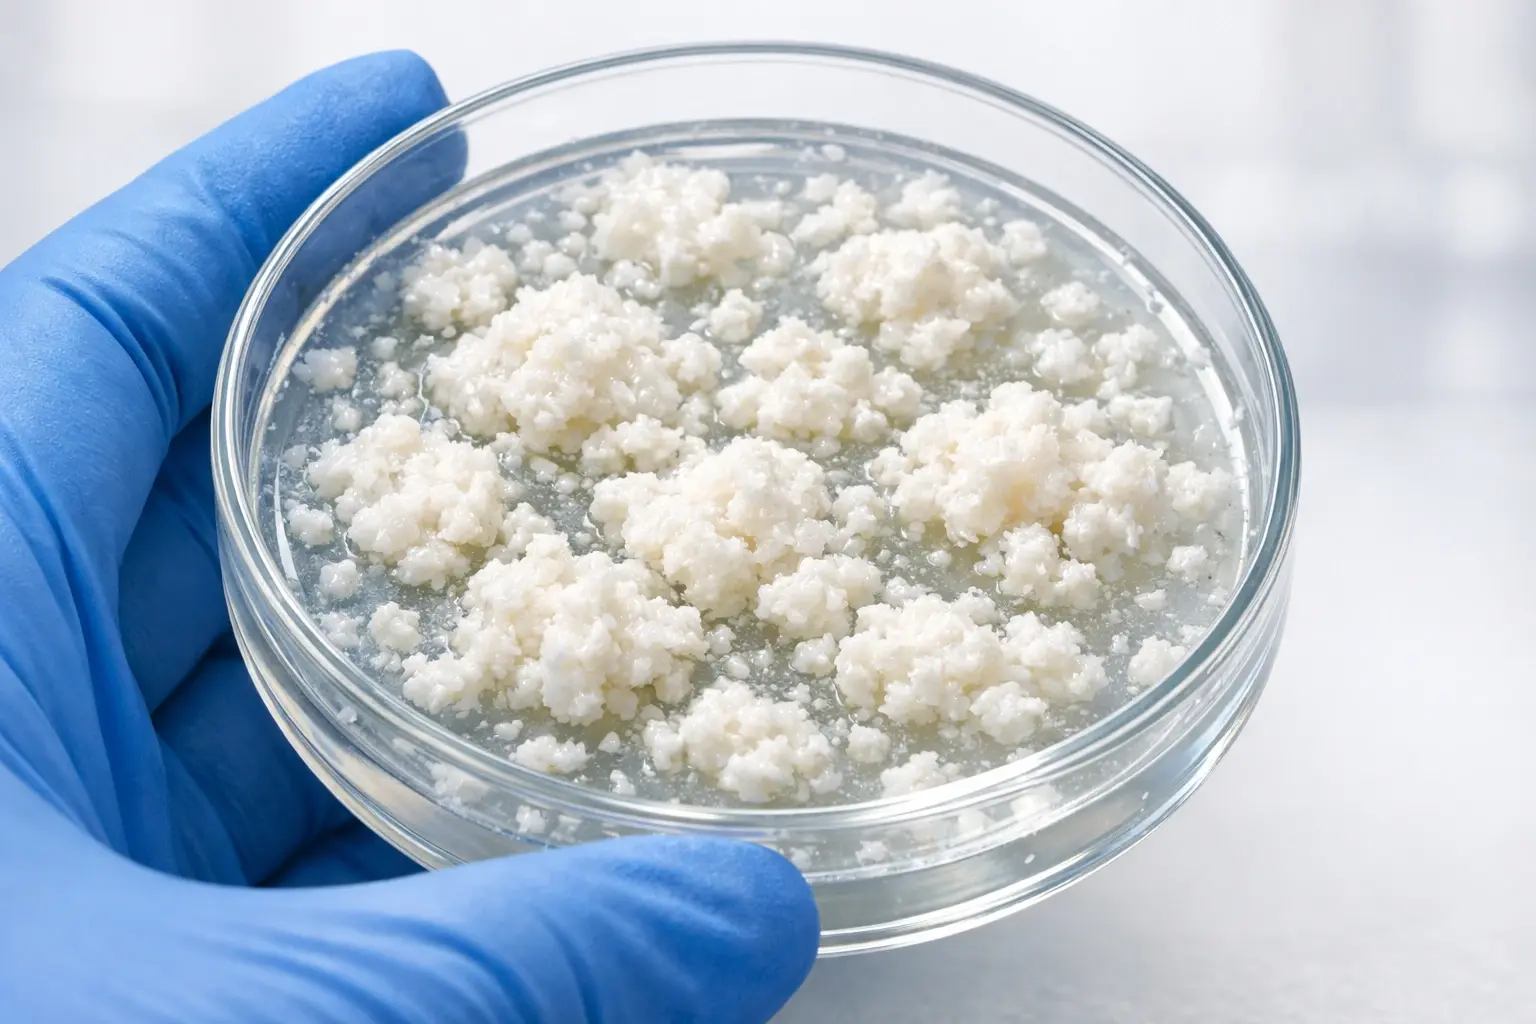
Изображение творожистых выделений, характерных для вагинального кандидоза

⚡️ Доверяй, но проверяй: ТОП-5 признаков хорошего врача в телеграм
Как понять, что у вас молочница
Опубликовано
Автор:
Солошина Наталья Сергеевна
Обновлено
На чтение
Просмотров
Об авторе
с 2015 года.
--
--
--
0
Краткий ответ: 3 главных признака молочницы
Чтобы быстро оценить свое состояние, обратите внимание на три классических симптома, которые чаще всего указывают на развитие молочницы. Появление даже одного из них - повод проявить бдительность.
- Творожистые выделения: густые, белые, без резкого запаха, по консистенции напоминающие творог.
- Сильный зуд и жжение: постоянный или периодический дискомфорт в области влагалища и вульвы, который может усиливаться ночью.
- Покраснение и отек: видимое раздражение и припухлость наружных половых органов.

Что такое молочница (вагинальный кандидоз) простыми словами?
Это не венерическое заболевание, а грибковая инфекция, которую вызывает избыточный рост грибков рода Candida. Нужно понимать, что эти микроорганизмы являются частью нормальной микрофлоры влагалища у многих женщин. Болезнь возникает только тогда, когда их количество резко увеличивается, нарушая естественный баланс.
«Важно понимать, что молочница - это сигнал о дисбалансе в организме, а не признак плохой гигиены. Моя задача как врача - не просто убрать симптом, а найти и устранить причину этого дисбаланса, чтобы здоровье моей хорошей пациентки было в полном порядке.»
Ключевые симптомы: подробный разбор
Симптомы молочницы могут проявляться по-разному, но есть несколько ключевых признаков, которые помогут вам сориентироваться.
Характер выделений: от классики до атипичных форм
Классические "творожистые" выделения: как они выглядят?
Самый узнаваемый признак - появление густых, белых, комковатых выделений. Они могут быть обильными или скудными, но их структура, напоминающая хлопья или крупинки творога, является ключевым маркером. Обычно они не имеют запаха или сопровождаются легким, едва уловимым кисловатым ароматом.
Нетипичные проявления: водянистые, желтоватые или скудные
Всегда ли при молочнице творожистые выделения? Нет, не всегда. Иногда, особенно при хронической форме или в самом начале заболевания, выделения могут быть более жидкими, водянистыми, беловато-желтого оттенка или настолько скудными, что женщина их почти не замечает, обращая внимание только на зуд.
Зуд, жжение и раздражение: интенсивность и локализация
От легкого дискомфорта до нестерпимого зуда
Зуд - пожалуй, самый изматывающий симптом. Его интенсивность варьируется от легкого периодического дискомфорта до нестерпимого, постоянного ощущения, которое мешает спать и вести привычный образ жизни. Часто зуд и жжение усиливаются после гигиенических процедур с мылом, во время или после полового акта, а также в ночное время.
Локализация: дискомфорт во влагалище и на наружных органах
Неприятные ощущения локализуются как внутри влагалища, так и на наружных половых органах (вульве), распространяясь на малые и большие половые губы.
Другие возможные признаки
- Покраснение, отек и трещинки на слизистой вульвы. Из-за постоянного зуда и воспаления слизистая становится красной, отечной и чувствительной. При тяжелом течении могут появляться микротрещины.
- Боль или дискомфорт при мочеиспускании. Это происходит не из-за инфекции в мочевом пузыре, а из-за контакта мочи с раздраженной и воспаленной слизистой вульвы.
- Боль во время полового акта (диспареуния). Воспаление и сухость слизистой делают половой контакт болезненным.
Это точно молочница? Сравнение с другими состояниями
Зуд и выделения - симптомы не только кандидоза. Крайне важно не ставить себе диагноз самостоятельно, так как можно спутать молочницу с другими, порой более серьезными заболеваниями.
Молочница и бактериальный вагиноз: главные отличия
Это две самые частые причины вагинального дискомфорта, но их природа и лечение кардинально различаются. Противогрибковые препараты не помогут при бактериальном вагинозе, и наоборот.
Как не спутать с ЗППП (трихомониаз, хламидиоз)
Нетипичные выделения (желтые, зеленоватые, пенистые), зуд и боль могут быть признаками инфекций, передающихся половым путем. Только лабораторный анализ мазка, назначенный врачом, может точно определить возбудителя и помочь подобрать правильное лечение.
Почему самодиагностика и самолечение опасны
Покупка разрекламированных «таблеток от молочницы» без точного диагноза может привести к серьезным последствиям. Вы рискуете не просто потратить деньги впустую, но и перевести заболевание в хроническую, трудноизлечимую форму. Кроме того, за маской молочницы может скрываться более опасное состояние, требующее совершенно иного подхода.
Когда нужно срочно обратиться к врачу?
Определенные ситуации требуют немедленного внимания специалиста. Не откладывайте визит, если вы столкнулись с одним из этих "красных флагов". Если у вас появились сомнения или симптомы вызывают сильное беспокойство, лучшим решением будет быстро обсудить это с гинекологом в онлайн формате, чтобы получить рекомендации и составить план действий.
- Симптомы молочницы появились у вас впервые.
- Вы беременны или предполагаете беременность.
- Вы отмечаете частые рецидивы (4 и более раз в год) - это может быть признаком хронической молочницы.
- Стандартное лечение, которое помогало раньше, не приносит облегчения.
- Появились новые, нетипичные симптомы: боль внизу живота, повышение температуры, кровянистые или гнойные выделения.
Почему возникает молочница: причины и факторы риска
Кандидоз - это не просто инфекция, а индикатор внутреннего состояния организма.
Главная причина: дисбаланс микрофлоры и рост грибка Candida
Основной "виновник" - грибок Candida albicans. Пока иммунная система и полезные лактобактерии во влагалище держат его популяцию под контролем, он безвреден. Сбой в этой системе защиты дает грибку "зеленый свет" для активного размножения.
Факторы-провокаторы, которые могут запустить процесс
- Прием антибиотиков: они уничтожают не только вредные, но и полезные бактерии, нарушая баланс микрофлоры.
- Ослабление иммунитета: хронический стресс, переутомление, простудные заболевания, а также состояния вроде ВИЧ-инфекции снижают защитные силы организма.
- Гормональные колебания: беременность, прием оральных контрацептивов (КОК) и естественные изменения цикла перед менструацией могут провоцировать рост грибка.
- Сахарный диабет: повышенный уровень сахара в крови создает идеальную питательную среду для Candida.
- Неправильная гигиена и белье: использование агрессивных средств для интимной гигиены, спринцевания, а также регулярное ношение тесного синтетического белья, создающего "парниковый эффект".
Диагностика и лечение: что делает врач
Правильное лечение начинается с точной диагностики. Не пытайтесь лечить молочницу дома по советам из интернета, доверьтесь профессионалу.
Как гинеколог подтверждает диагноз
- Осмотр: во время осмотра на гинекологическом кресле врач визуально оценивает состояние слизистых влагалища и вульвы, характер выделений.
- Микроскопия мазка: это золотой стандарт диагностики. Врач берет мазок со слизистой, и под микроскопом в лаборатории лаборант обнаруживает нити мицелия грибка, что и подтверждает диагноз "вагинальный кандидоз". При необходимости может быть проведен посев для определения конкретного вида Candida и его чувствительности к препаратам.
Общие принципы лечения (обзорно)
Лечение молочницы направлено на подавление роста грибковой инфекции. Врач подбирает схему индивидуально, учитывая тяжесть симптомов и историю болезни. Обычно используются противогрибковые (антимикотические) препараты в виде вагинальных свечей, кремов, мазей или таблеток для приема внутрь.
Нужна быстрая и квалифицированная помощь?
Если симптомы вызывают беспокойство, а возможности посетить клинику сейчас нет, вы можете получить онлайн-консультацию, чтобы обсудить симптомы и определить дальнейшие шаги.
Виды и формы кандидоза
Для подбора правильной тактики лечения важно понимать, с какой формой заболевания мы имеем дело.
Неосложненная (острая) форма
Это единичные эпизоды молочницы с легкими или умеренными симптомами, которые возникают реже 4 раз в год. Обычно они хорошо поддаются стандартному короткому курсу лечения.
Осложненная форма (рецидивирующая, тяжелая)
Сюда относят рецидивирующую молочницу (4 и более эпизодов в год), случаи с тяжелыми симптомами (выраженный отек, трещины, язвочки) или кандидоз, вызванный нетипичными видами грибка (не-albicans). Такая форма требует более длительного и комплексного лечения.
Профилактика: как снизить риск рецидивов
- Соблюдайте правила интимной гигиены: используйте мягкие средства без отдушек, подмывайтесь по направлению спереди назад, не прибегайте к спринцеваниям без назначения врача.
- Выбирайте правильное белье: отдавайте предпочтение трусикам из натуральных, дышащих тканей (хлопок) и не носите тесное белье постоянно.
- Пересмотрите диету: обсудите с врачом, стоит ли ограничивать потребление сахара, сдобы и продуктов, вызывающих брожение. Хотя прямая связь диеты и молочницы до конца не доказана для всех женщин, некоторым такая коррекция помогает снизить частоту рецидивов.
Часто задаваемые вопросы
Поделиться:
Задать вопрос гинекологу онлайн
Готовы решить вопрос сегодня?
Оставьте контактные данные, и оператор свяжется в течение 5 минут в Telegram/ What'sApp
Оставьте контактные данные, и оператор свяжется в течение 5 минут в Telegram/ What'sApp
Читайте также:
Проверь себя
Болит, а врачи разводят руками?
Возможно, причина в эмоциях
Бесплатный чек-лист
по симптомам психосоматики в гастроэнтерологии:
по симптомам психосоматики в гастроэнтерологии:
- Боли в животе.
- Изжога.
- Тошнота, рвота и отрыжка.
Нажимая на кнопку, вы соглашаетесь
с Политикой конфиденциальности, Согласием на обработку персональных данных.
с Политикой конфиденциальности, Согласием на обработку персональных данных.

